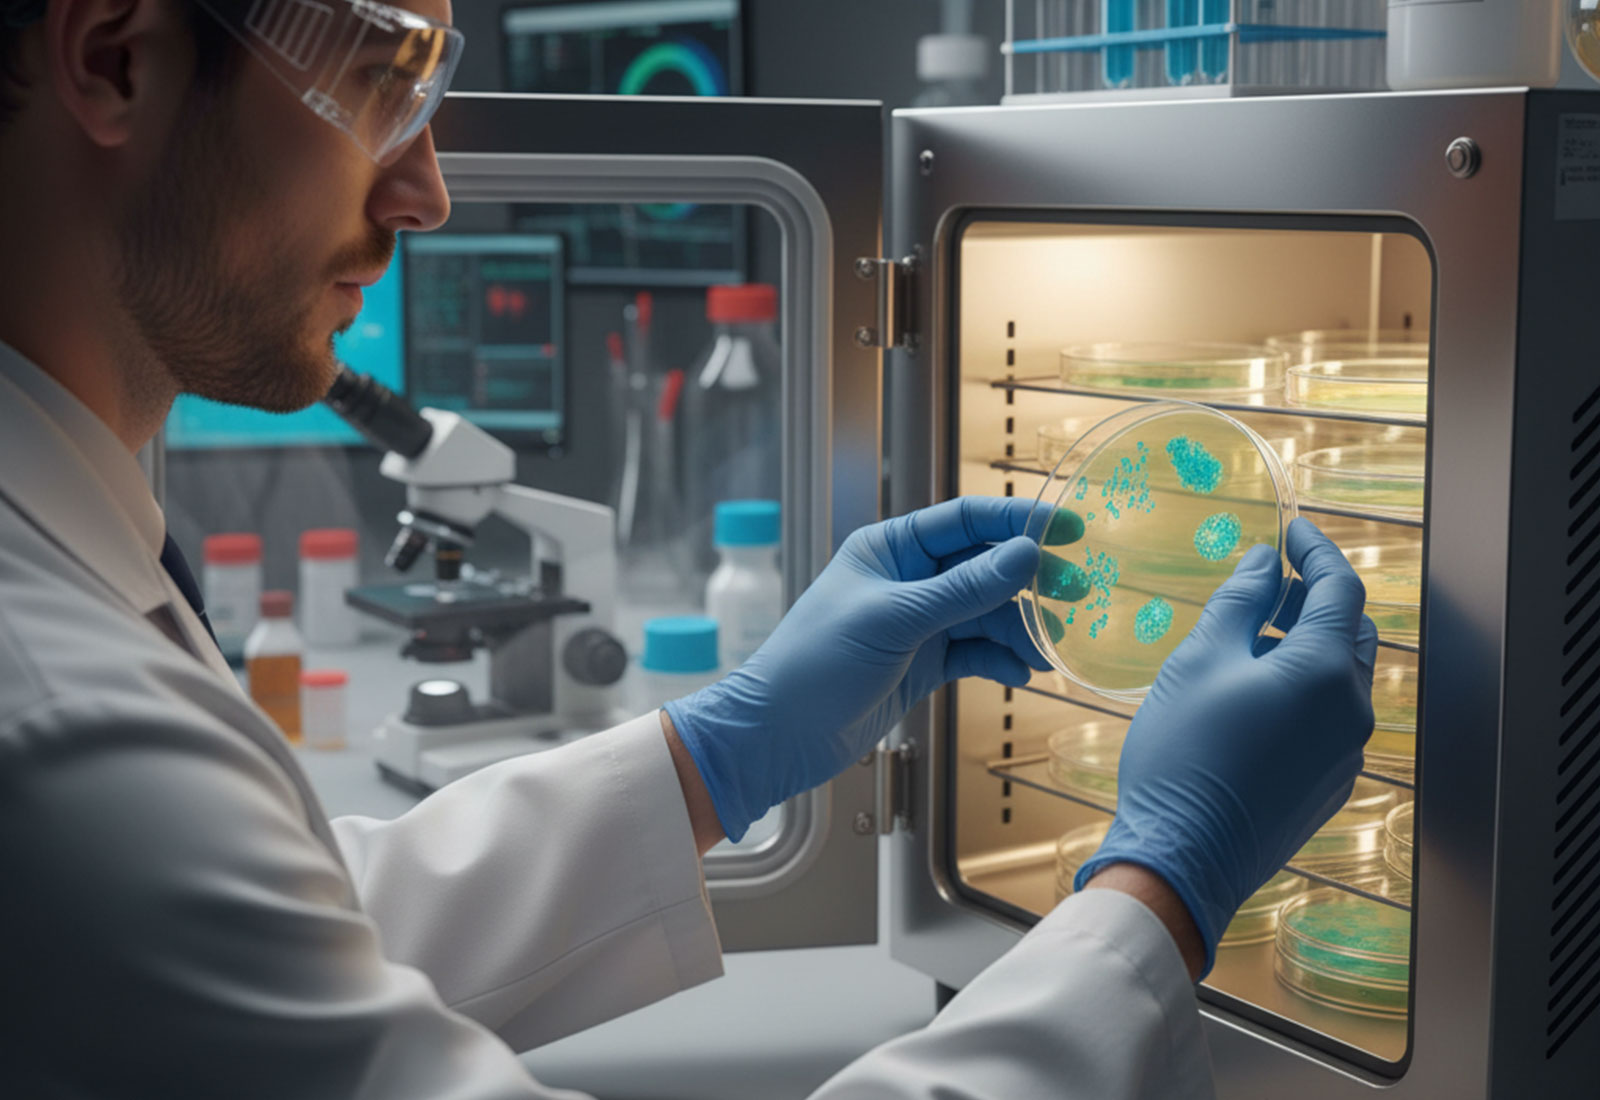
doorlux

Welcome to doorlux
We Craft Your Dream
Home Into Reality
In addition to creating stylish products that improve your home, we also offer bespoke service. In order to deliver a high-quality product
Welcome to doorlux
We Craft Your Dream
Home Into Reality
In addition to creating stylish products that improve your home, we also offer bespoke service. In order to deliver a high-quality product
Welcome to dreamhub
We are a creative
Design Agency
Pellentesque at posuere tellus phasellus scelerisque porem.
About Company
LABOHUB BIO
We are a laboratory equipment and scientific instrument supplier headquartered in Shanghai, China, dedicated to providing diverse laboratory solutions across various industries. Our brand LABOHUB specializes in high-quality laboratory products, while its sub-brand LABOHUBBIO focuses primarily on general equipment for biological laboratories, with particular emphasis on molecular biology laboratories.
Our company has established close partnerships with multiple factories possessing extensive export manufacturing experience, forming a well-integrated supply chain system with a broad product range to meet the majority of laboratory procurement needs. At the same time, we strive to offer the most competitive prices in the market for products with equivalent technical specifications.
Certified Company
ISO 9002:2017.
Call Quality Services
1600-545-6457
Book windows & door Inspection
*Your roof will require some professional attention for long live.
Our Services
We Provide
Trendy Home & Door Services
In Person Estimates No Bait & Switch
Qualified & Insured Technicians
Garage Door Drum Replacement
Emergency Service or Same Day Service
Broken Garage Door Springs
Commercial Overhead Door Service
Why Choose Us
Reason For
People Choosing DoorLux
Benefits of choosing
our company
Premium Quality
We Install High- Grade
Doors & Windows
Curabitur accumsan iaculis neque, sit amet scelerisque eros. Phas hendrerit Curabitur accumsan iaculis neque, sit amet


Latest Projects
Inspiration
On Your Next Project
Recent Articles
Our Latest
News & Updates

Vitae magnis fusce laoreet porttitor hampden sydney
Curabitur accumsan iaculis neque, sit amet sceleris Phasellus hendrerit neque a augue scelerisque end

Sed ut perspiciatis unde omnis iste natusli
Curabitur accumsan iaculis neque, sit amet sceleris Phasellus hendrerit neque a augue scelerisque end

Dignissimos Ducimus Qui Blanditiis Prae sentium Voluptatum
Curabitur accumsan iaculis neque, sit amet sceleris Phasellus hendrerit neque a augue scelerisque end